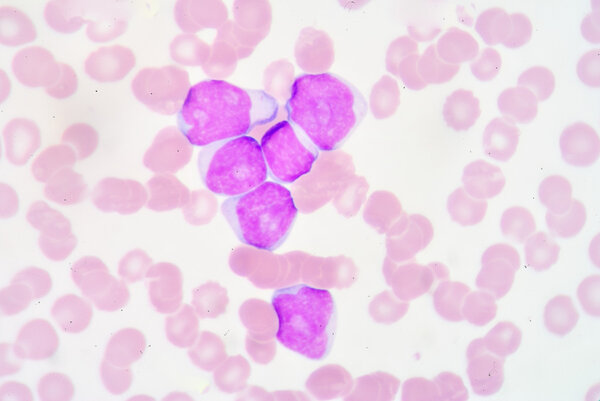
Lymphoblast
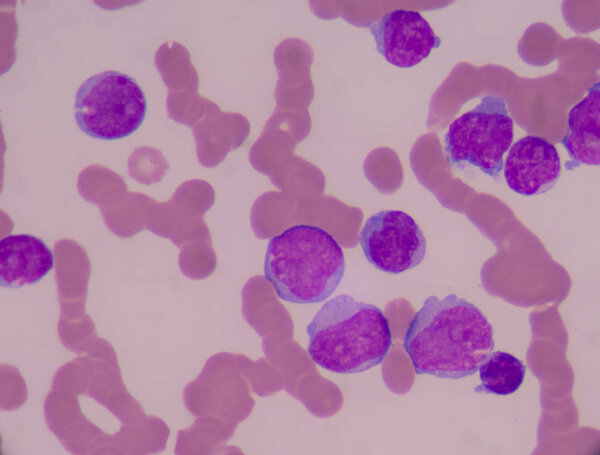
Blood smear show immature white blood cells.Leukemia
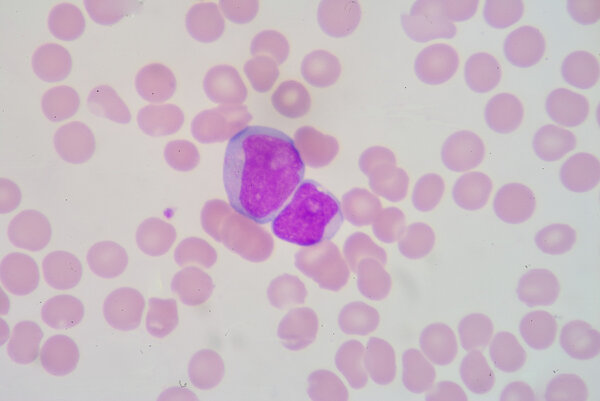
Lymphoblast
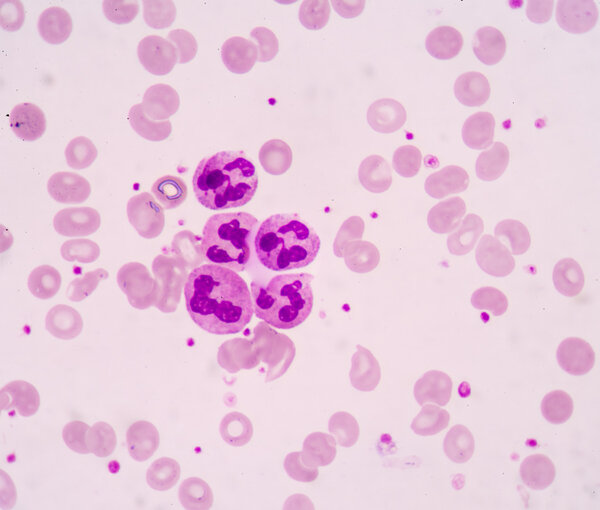
Hypersegmented neutrophil.White blood cells of a human, photomicrograph panorama as seen under the microscope
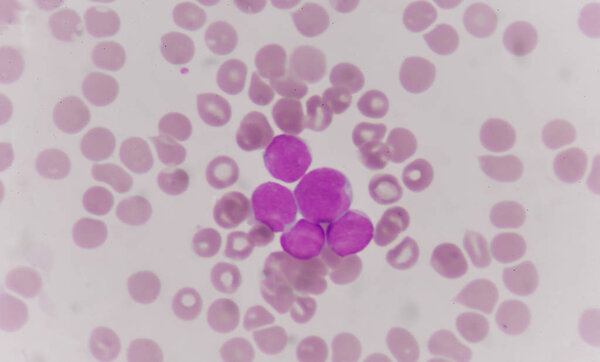
blood smear is often used as a follow-up test

- /
- Search /
- Lymphoblast
Lymphoblast
A blood smear is often used as a follow-up test to abnormal results on a complete blood count (CBC) to evaluate the different types of blood cells.
image
image
Jan.27, 2015 06:26:34
10.04
0.67
335x500
669x1000
1339x2000
2592x3872
2592x3872
474
3
toeytoey
HUMAN HEALTH BLOOD MEDICINE MEDICAL CELL DISEASE BIOLOGY LAB LABORATORY NUCLEUS ORGANISM SLIDE NORMAL MICROSCOPE MICROBIOLOGY INFECTION GRANULES GRANULATED ABNORMAL LEUKOCYTE PATHOLOGY BACTERICIDAL HEMATOLOGY ANTIGEN EOSINOPHIL NEUTROPHIL BASOPHIL LOBED CYTOPLASM ON WHITE BONE MARROW RED BLOOD CELL WHITE BLOOD CELL GRANULOCYTE IMMUNE SYSTEM MYELOBLAST LYMPHOBLAST PHAGOCYTES IMMUNE RESPONSE MICROCYTE BAND PMN BLOOD SMEAR SEGMENTED PMN METAMYELOCYTE PROMYELOCYTE MACROCYTE MYELOCYTE BLAST CELL